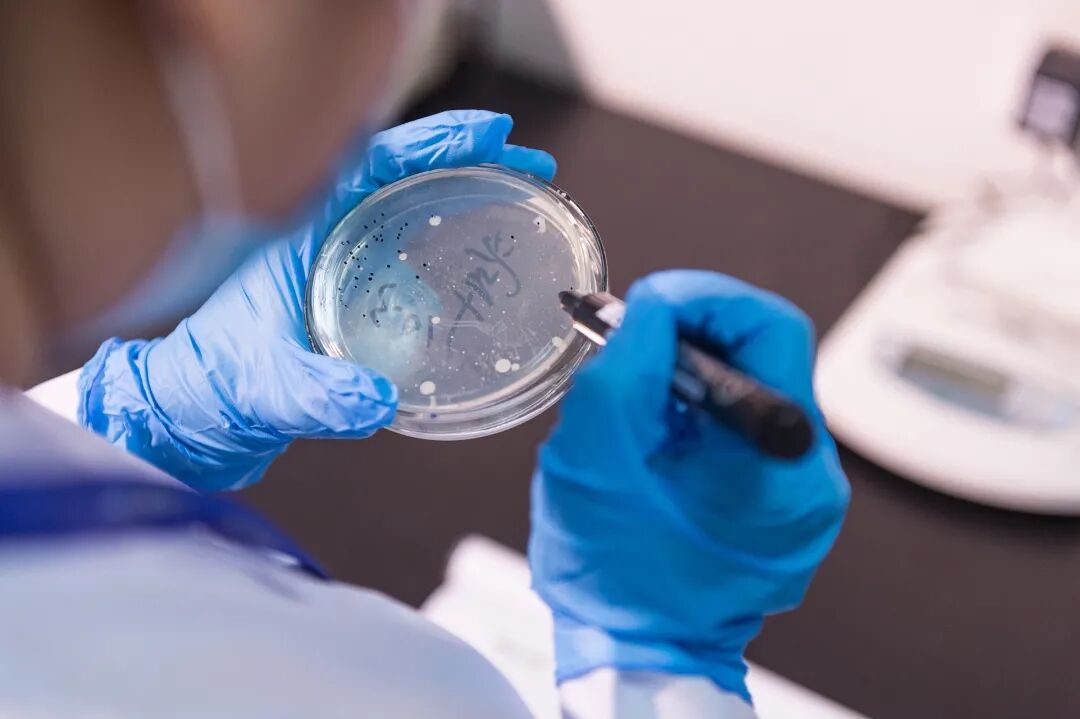

随着HACCP 危害分析与关键控制点体系认证
和ISO22000 食品安全管理体系认证
两大体系证书落地
家乐福在食品安全把关上高度又更上一层

(小福给大家简单普及一下两个证书)
HACCP 危害分析与关键控制点体系认证


HACCP体系是国际上共同认可和接受的食品安全保证体系,主要是对食品中微生物、化学和物理危害进行安全控制。最早是用于为太空作业的宇航员提供食品安全方面的保障,家乐福坚决执行与国际接轨的高标准。
HACCP 危害分析与关键控制点体系认证


ISO22000认证是描述食品安全管理体系要求的使用指导标准,适用于整个食品供应链中所有的组织,包括饲料加工、初级产品加工、到食品的制造、运输和储存、以及零售商和饮食业。在食品部门专家的参与下开发,包含了全球各类食品零售商关键标准的要求。
通过以上认证的门店
可将食品安全危害降低至最小或可接受的水平
同时建立可追溯系统和不安全产品实施撤回机制
确保时刻满足所有食品安全法规的要求
目前家乐福旗下5家商业公司
已获得食品安全双体系证书
家乐福在食品安全上的每一个新举措
都代表着对消费者生命健康的高度关注
对客户在经营上的谨慎与不懈努力
Food Safety
同时,家乐福在食品安全上的坚实基础还包括
NO.1
自2011年起,在政府相关机构的支持和关怀下,家乐福陆续在北京、沈阳、重庆、上海建立了4大食品安全检测中心及覆盖全国多家门店的30余个迷你实验室的实验室网络,拥有气相色谱仪、液相色谱仪、原子吸收/荧光分光光度计等仪器分析领域核心设备,是中国零售行业内唯一具有大型仪器分析检测能力的实验室系统
NO.2
利用全链路数字化形式开展线上线下的教育培训,建设矩阵式培训体系,培训内容按不同层级定制并不断优化
NO.3
通过科学交流、合作以及创新支持中国食品安全、营养和健康发展
NO.4
拥有先进质量管理系统QMS
NO.5
对于不合格产品处理零容忍,品控中心质量部收到调查结果后30分钟内发出下架通知,全国门店关负责人收到撤架通知后2小时内执行并完成下架
NO.6
拥有完备的重大食品安全及质量事件管理流程,具备成熟的不合格事件处理能力


荣誉墙

● 截止2019年11月,共26家门店荣获政府“放心肉菜超市”荣誉
● 2011-2019,荣获中国食品健康七星公约联盟颁发的“中国食品健康七星奖”(或七星企业奖)
● 2015-2016,在年度中国放心食品大会上,荣获“放心食品渠道奖”